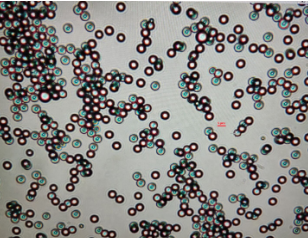

聚苯乙烯红色/绿色/蓝色荧光微球(彩色聚苯乙烯荧光微球)
红色荧光微球

聚苯乙烯荧光微球具有荧光强度高,性能稳定,粒径分布窄等特性,可广泛用于医疗诊断、血流测定、示踪、体内成像,以及成像仪器和流式细胞仪的校准。因为,我们的染料并非仅仅是结合在微球表面上,而是填充到微球内部,所以它们相对不易受光漂白作用和其他环境因子的影响,微球就算经过高速离心,也不会发生染料泄露。羧基化修饰的微珠表面有高密度的均匀分布的羧酸,这使得它们适合于通过诸如碳化二亚胺(EDAC)等水溶性的亚胺类试剂共价偶合蛋白质和其他含有胺基的生物分子。
荧光微球主要特点
进口荧光染料分子包埋在微球内部基质中集中发光,荧光信号更加稳定
可接受不同表面官能团以及不同规格大小的定制(20nm-100um)
填充了近10%的荧光染料,确保了荧光信号的高强度,高亮度
粒径高度均一(CV%小于5%),批间差小,重复性好
荧光微球技术参数
成分:含有荧光染料聚苯乙烯(FluorescencePolystyrene)
密度:1.05g/cm3
折射指数:1.59@589nm(25°C)
添加剂:含有微量的表面活性剂
绿色荧光微球

聚苯乙烯荧光微球具有荧光强度高,性能稳定,粒径分布窄等特性,可广泛用于医疗诊断、血流测定、示踪、体内成像,以及成像仪器和流式细胞仪的校准。因为,我们的染料并非仅仅是结合在微球表面上,而是填充到微球内部,所以它们相对不易受光漂白作用和其他环境因子的影响,微球就算经过高速离心,也不会发生染料泄露。羧基化修饰的微珠表面有高密度的均匀分布的羧酸,这使得它们适合于通过诸如碳化二亚胺(EDAC)等水溶性的亚胺类试剂共价偶合蛋白质和其他含有胺基的生物分子。
荧光微球主要特点
进口荧光染料分子包埋在微球内部基质中集中发光,荧光信号更加稳定
可接受不同表面官能团以及不同规格大小的定制(20nm-100um)
填充了近10%的荧光染料,确保了荧光信号的高强度,高亮度
粒径高度均一(CV%小于5%),批间差小,重复性好
荧光微球技术参数
成分:含有荧光染料聚苯乙烯(FluorescencePolystyrene)
密度:1.05g/cm3
折射指数:1.59@589nm(25°C)
添加剂:含有微量的表面活性剂
蓝色荧光微球
聚苯乙烯荧光微球具有荧光强度高,性能稳定,粒径分布窄等特性,可广泛用于医疗诊断、血流测定、示踪、体内成像,以及成像仪器和流式细胞仪的校准。因为,我们的染料并非仅仅是结合在微球表面上,而是填充到微球内部,所以它们相对不易受光漂白作用和其他环境因子的影响,微球就算经过高速离心,也不会发生染料泄露。羧基化修饰的微珠表面有高密度的均匀分布的羧酸,这使得它们适合于通过诸如碳化二亚胺(EDAC)等水溶性的亚胺类试剂共价偶合蛋白质和其他含有胺基的生物分子。
荧光微球主要特点
进口荧光染料分子包埋在微球内部基质中集中发光,荧光信号更加稳定
可接受不同表面官能团以及不同规格大小的定制(50nm-100um)
填充了近10%的荧光染料,确保了荧光信号的高强度,高亮度
粒径高度均一(CV%小于5%),批间差小,重复性好
荧光微球技术参数
成分:含有荧光染料聚苯乙烯(FluorescencePolystyrene)
密度:1.05g/cm3
折射指数:1.59@589nm(25°C)
添加剂:含有微量的表面活性剂
荧光色彩:高亮蓝色荧光
直径:50nm-100um
表面官能团:COOH
荧光光谱特性:激发波长:400nm,发射波长:450nm
保存条件:2-8度冷藏,避光
包装规格1ml,5ml,50ml
要求陈述:产品尺寸规格及表面官能团可定制
彩色荧光微球

彩色微球色彩逼真,染料填充微球内部,不易发生色彩漂白,批次稳定性好,有多种规格可供选择,我们也接受定制服务。彩色微球中常用于侧向层析实验和胶乳凝集试验。我们的彩色聚苯乙烯微球填充了**,对比度高的油溶性染料,我们的调色板颜色代表我们色彩鲜亮的标准。非官能团化和羧基化的微球支持物理吸附和共价结合的不同方法,规格颜色及官能团可定制。
彩色微球主要特点
粒径尺寸的选择在0.1μm至0.5μm
可接受不同大小,不同颜色以及不同表面修饰的定制
填充了近20%的油溶性彩色染料,对比度高,颜色深
粒径高度均一(CV%小于5%),批间差小,重复性好
彩色微球技术参数
成分:含有彩色染料的聚苯乙烯(DyedPolystyrene)
密度:1.05g/cm3
折射指数:1.59@589nm(25°C)
添加剂:含有微量的表面活性剂
齐岳供应微球试剂:
聚苯乙烯磁性微球
聚苯乙烯磁性微球-NH2
聚苯乙烯磁性微球-COOH
聚苯乙烯磁性微球-Epoxy
聚苯乙烯磁性微球-SiOH
单分散交联聚苯乙烯微球
交联聚苯乙烯微球 粒径4μm-22 μm
羧基交联聚苯乙烯微球 粒径4μm-25μm
氨基交联聚苯乙烯微球 粒径 4μm-220 μm
"单分散甲基丙烯酸环氧丙脂 (GMA) 微球 GMA微球 粒径0.3 μ m-9.0μ m"
红色荧光微球
橙色荧光微球
绿色荧光微球
氨基红色荧光微球
氨基橙色荧光微球
氨基绿色荧光微球
羧基红色荧光微球
羧基橙色荧光微球
羧基绿色荧光微球
单分散稀土荧光微球
红色光单分散稀土荧光微球 较大激发波长395 nm 较大发射波长630 nm 粒径2.0μm-5.0μm
羧基修饰单分散稀土荧光微球 较大激发波长395 nm 较大发射波长630 nm 粒径2.0μm->2.0μm
荧光纳米微球
红色乳胶微球
蓝色乳胶微球
黄色乳胶微球
绿色乳胶微球
紫色乳胶微球
单分散荧光微球
红色/橙色/绿色聚苯乙烯荧光微球 较大激发波长620 nm-443 nm
红色/橙色/绿色聚苯乙烯荧光微球 较大发射波长680 nm-505 nm
红色/橙色/绿色氨基聚苯乙烯荧光微球 较大激发波长620 nm-443 nm
红色/橙色/绿色氨基聚苯乙烯荧光微球 较大发射波长680 nm-505 nm
红色/橙色/绿色羧基聚苯乙烯荧光微球 较大激发波长620 nm-443 nm
红色/橙色/绿色羧基聚苯乙烯荧光微球 较大发射波长680 nm-505 nm
红色/橙色/绿色二氧化硅荧光微球 较大激发波长620 nm-443 nm
红色/橙色/绿色二氧化硅荧光微球 较大发射波长680 nm-505 nm
红色乳胶微球 粒径100nm-700nm 1.0μm-10.0μm
蓝色乳胶微球 粒径100nm-700nm 1.0μm-10.0μm
黄色乳胶微球 粒径100nm-700nm 1.0μm-10.0μm
绿色乳胶微球 粒径100nm-700nm 1.0μm-10.0μm
黑色乳胶微球 粒径100nm-700nm 1.0μm-10.0μm
紫色乳胶微球 粒径100nm-700nm 1.0μm-10.0μm
"Eu-时间分辨荧光纳米微球 聚苯乙烯-羧基PS(-COOH)"
"Eu-时间分辨荧光纳米微球 聚苯乙烯-亲和素PS(-SA)"
"Sm-时间分辨荧光纳米微球 聚苯乙烯-羧基PS(-COOH)"
"彩色微球(红色/粉色/橙色/黄色/绿色/蓝色/黑色) 聚苯乙烯-羧基PS(-COOH)"
"磁性微球 聚苯乙烯-羧基PS(-COOH)"
"PS纳米微球/空白微球 聚苯乙烯-羧基PS(-COOH)"
天然高分子微球
淀粉微球
白蛋白微球
明胶微球
壳聚糖微球
纳米微球
免疫比浊微球
载药微球
微流控微球
热塑性膨胀微球
空心玻璃微球
醋酸奥曲肽微球
微球蛋白
胶体金微球
气凝胶微球
二氧化硅气凝胶微球
纤维素气凝胶微球
间苯二酚-甲醛/碳气凝胶微球
石墨烯气凝胶微球
微球脂质体
营养物纳米微球
钇90树脂微球
补偿微球
中间相炭微球
脲醛树脂磁性微球
活性炭微球
三氧化二铁磁性微球
四氧化三铁磁性纳米微球
氨基酸聚合物磁性微球
多糖磁性微球
聚合物磁性微球
上述产品齐岳生物均可供应,仅用于科研!
小编:wyf 07.01




 齐岳微信公众号
齐岳微信公众号
 官方微信
官方微信
 库存查询
库存查询